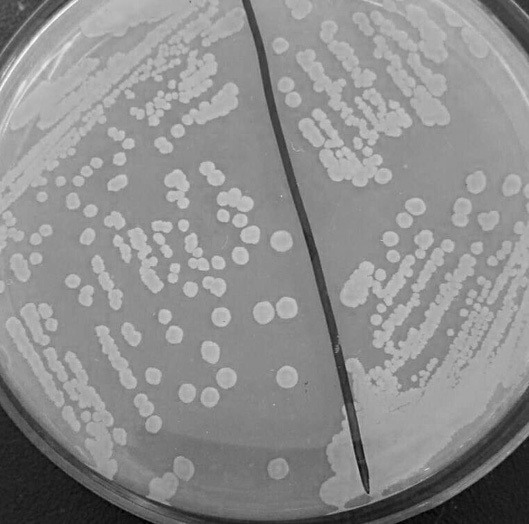
一种短小芽孢杆菌fe05及其应用-爱企查
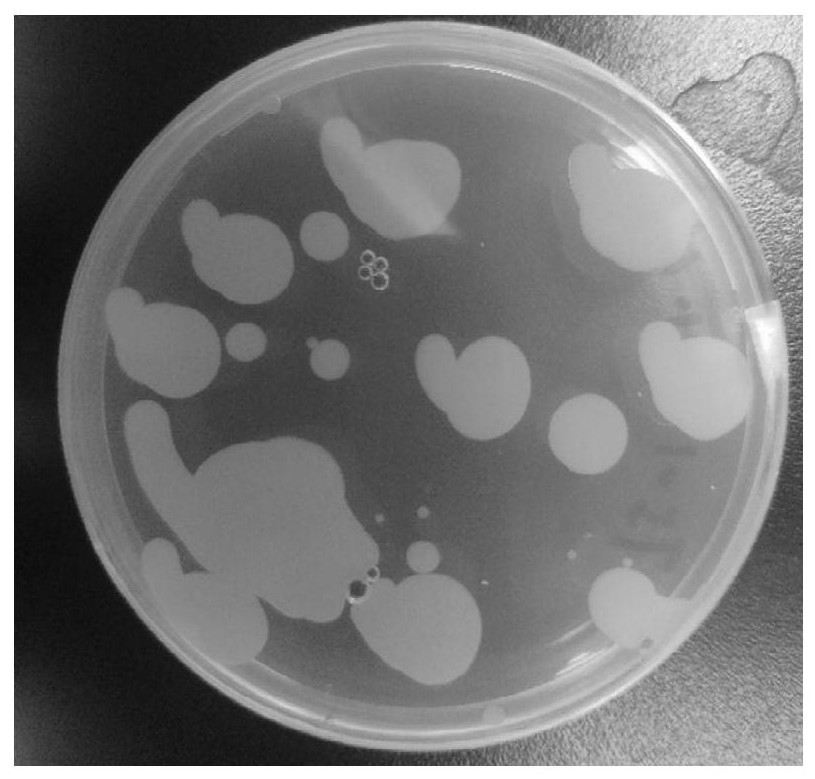
一株短小芽孢杆菌t51及其应用

短小芽孢杆菌

芽孢杆菌
图片尺寸1200x784
一种短小芽孢杆菌及其在镉污染修复中的应用制造技术
图片尺寸995x1000
芽孢杆菌镜检图
图片尺寸640x480
新的短短芽孢杆菌菌株,培养方法及其应用技术
图片尺寸880x734
一种饲用短小芽孢杆菌及其应用的制作方法
图片尺寸1000x949
芽孢杆菌酵母菌酵母菌在水产养殖的用途主要在幼鱼幼虾的开口饵料
图片尺寸800x602
波茨坦短芽孢杆菌
图片尺寸361x206
一种短小芽孢杆菌及其应用
图片尺寸1150x627
ps:杆菌污染爆发图片: 查看 格蓝染色阳性,长杆状,并且中间可见
图片尺寸2272x1704
芽孢杆菌属
图片尺寸267x300
枯草芽孢杆菌杀菌图片
图片尺寸400x300
芽孢杆菌
图片尺寸754x1008
耐碱性短小芽孢杆菌木聚糖酶在枯草杆菌中的表达及发酵条件优化
图片尺寸960x1280
芽孢杆菌
图片尺寸640x474
一种防治稻曲病的短小芽孢杆菌的制作方法
图片尺寸1000x993
一株荔枝内生短小芽孢杆菌及其在荔枝霜疫病防治的应用的制作方法
图片尺寸997x1000
精品芽孢杆菌的选择与应用
图片尺寸800x600
一种短小芽孢杆菌fe05及其应用-爱企查
图片尺寸529x524
短小杆菌属
图片尺寸268x279
一株短小芽孢杆菌t51及其应用
图片尺寸815x779
猜你喜欢:芽孢杆菌巨大芽孢杆菌凝结芽孢杆菌芽孢杆菌图片地衣芽孢杆菌贝莱斯芽孢杆菌蜡样芽孢杆菌炭疽芽孢杆菌纳豆芽孢杆菌凝结芽孢杆菌活菌片苏云金芽孢杆菌多粘类芽孢杆菌解淀粉芽孢杆菌蜡样芽孢杆菌片蜡样芽孢杆菌活菌胶囊地衣芽孢杆菌活菌颗粒地衣芽孢杆菌活菌胶囊地衣芽孢杆菌胶囊炭疽芽孢杆菌图片苏云金芽孢杆菌图片芽孢杆菌图片显微镜炭疽芽孢杆菌革兰染色芽孢杆菌图片手绘图炭疽芽孢杆菌手绘图短小精短小短小症短小精干四肢短小男性短小图片淘宝退货成功图片小花仙薰衣草精灵王奶茶加寒天犬夜叉神乐高清壁纸荣耀magic pencil非诚勿扰第一期延时阀图片图形符号长肉髻钱扇子女生挡脸头像 自拍华为mate40x7.2寸箭羽毛